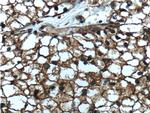
SEPT2 Antibody in Immunohistochemistry (Paraffin) (IHC (P))
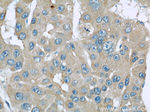
SEPT2 Antibody in Immunohistochemistry (Paraffin) (IHC (P))

Search
Proteintech
SEPT2 Monoclonal Antibody (2F3B2)
{{$productOrderCtrl.translations['antibody.pdp.commerceCard.promotion.promotions']}}
{{$productOrderCtrl.translations['antibody.pdp.commerceCard.promotion.viewpromo']}}
{{$productOrderCtrl.translations['antibody.pdp.commerceCard.promotion.promocode']}}: {{promo.promoCode}} {{promo.promoTitle}} {{promo.promoDescription}}. {{$productOrderCtrl.translations['antibody.pdp.commerceCard.promotion.learnmore']}}
产品信息
60075-1-IG
种属反应
已发表种属
宿主/亚型
分类
类型
克隆号
抗原
偶联物
形式
浓度
规格
纯化类型
保存液
内含物
保存条件
运输条件
产品详细信息
Immunogen sequence: MSKQQPTQF INPETPGYVG FANLPNQVHR KSVKKGFEFT LMVVGESGLG KSTLINSLFL TDLYPERVIS GAAEKIERTV QIEASTVEIE ERGVKLRLTV VDTPGYGDAI NCRDCFKTII SYIDEQFERY LHDESGLNRR HIIDNRVHCC FYFISPFGHG LKPLDVAFMK AIHNKVNIVP VIAKADTLTL KERERLKKRI LDEIEEHNIK IYHLPDAESD EDEDFKEQTR LLKASIPFSV VGSNQLIEAK GKKVRGRLYP WGVVEVENPE HNDFLKLRTM LITHMQDLQE VTQDLHYENF RSERLKRGGR KVENEDMNKD QILLEKEAEL RRMQEMIARM QAQMQMQMQG GDGDGGALGH HV (1-361 aa encoded by BC014455)
靶标信息
Septin 2 is a filament-forming cytoskeletal GTPase. Septin 2 is required for normal organization of the actin cytoskeleton and plays a role in the biogenesis of polarized columnar-shaped epithelium by maintaining polyglutamylated microtubules, thus facilitating efficient vesicle transport, and by impeding MAP4 binding to tubulin. It is required for the progression through mitosis, and it forms a scaffold at the midplane of the mitotic splindle required to maintain CENPE localization at kinetochores and consequently chromosome congression. During anaphase, Septin 2 may be required for chromosome segregation and spindle elongation. Septin 2 also plays a role in ciliogenesis and collective cell movements.
仅用于科研。不用于诊断过程。未经明确授权不得转售。
生物信息学
蛋白别名: 2-Sep; epididymis secretory sperm binding protein; KIAA0158; NEDD-5; Neural precursor cell expressed developmentally down-regulated protein 5; neural precursor cell expressed, developmentally down-regulated 5; neural precursor cell expressed, developmentally down-regulated gene 5; Septin-2; unnamed protein product; Vascular endothelial cell specific protein 11
基因别名: AW208991; DIFF6; hNedd5; KIAA0158; mKIAA0158; NEDD-5; NEDD5; Pnutl3; SEPT2; Septin-2; SEPTIN2; Vesp11
UniProt ID: (Human) Q15019, (Mouse) P42208, (Rat) Q91Y81
Entrez Gene ID: (Human) 4735, (Mouse) 18000, (Rat) 117515